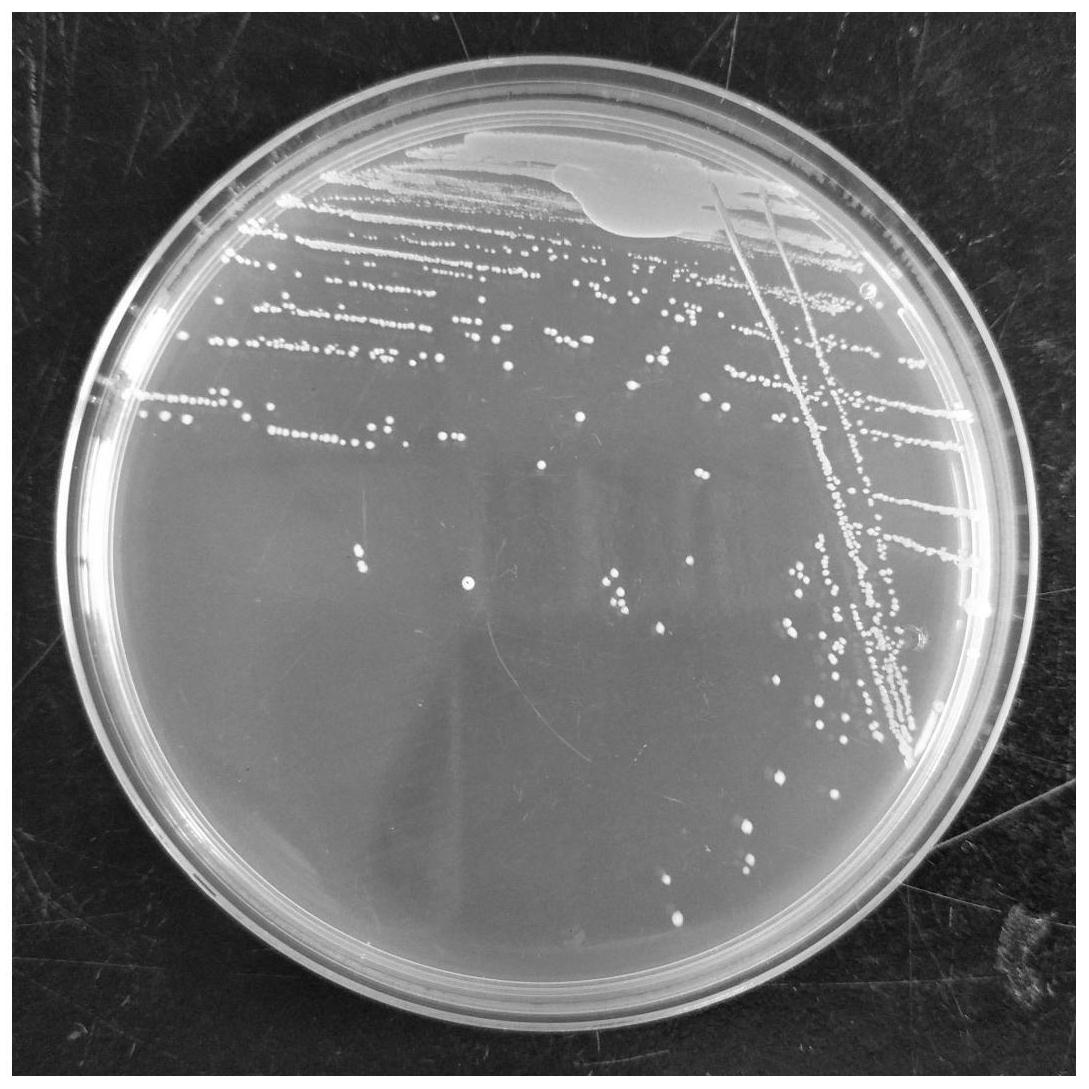
一株可高产硒代半胱氨酸的副干酪乳杆菌及其应用

副干酪乳杆菌

副干酪乳杆菌|北纳生物
图片尺寸500x375
益可劲副干酪乳杆菌
图片尺寸474x265
一种副干酪乳杆菌及其在宠物犬犬粮中的应用
图片尺寸1109x1081
副干酪乳杆菌
图片尺寸360x360
什么是副干酪乳杆菌.今天进入第5条笔记,要为大家介绍的是"副 - 抖音
图片尺寸1080x1440
副干酪乳杆菌及其在制备治疗溃疡性结肠炎药物中的应用
图片尺寸953x835
干酪乳杆菌
图片尺寸1280x1280
副干酪乳杆菌lp-33冻干粉益生菌mrs肉汤培养基30度静置扩繁菌液
图片尺寸800x800
干酪lcaseizhang口服干酪乳杆菌对肾脏损伤的影响
图片尺寸500x365
一株可高产硒代半胱氨酸的副干酪乳杆菌及其应用
图片尺寸1089x1089
干酪乳杆菌
图片尺寸800x600
副干酪乳杆菌jlpf176star菌株活性益生菌冻干粉膳食补充原料
图片尺寸800x800
副干酪乳杆菌hd1.7prcr基因sirna制造技术
图片尺寸1000x955
益可维副干酪乳杆菌k9与进口菌株相比更具优势_肠道_免疫_功能
图片尺寸658x386
益生菌研究副干酪乳杆菌lc01
图片尺寸600x300
干酪乳杆菌
图片尺寸400x300
畅乐敏副干酪杆菌lp33即食型乳酸菌过敏体质益生益生菌
图片尺寸800x800
副干酪乳杆菌株lbp-ye01,其培养物,其菌液,传代菌株挑选和保藏方法
图片尺寸1000x958
一株可高产硒代半胱氨酸的副干酪乳杆菌及其应用的制作方法
图片尺寸1000x1000
干酪乳杆菌冻干粉
图片尺寸600x418